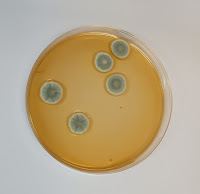

Què passaria si un bon dia tots els microorganismes que treballen per nosaltres es declaressin en vaga? Si cansats de ser explotats, de viure sota la pressió d'haver de mantenir el ritme de producció, aturessin la seva multiplicació i el seu metabolisme? Hi pensa mentre comprova el funcionament del bioreactor, on milions de bacteris creixen i es multipliquen exponencialment. S'imagina a mestres formatgers, iogurters i enòlegs desconcertats en veure formatges que no maduren, llet que no forma iogurt, tines on el most no fermenta. S'imagina a tècnics de laboratori desesperats perquè no obtenen els cultius desitjats, aturant-se la producció d'antibiòtics, de vacunes, de probiòtics, de biofertilitzants i biopesticides. Realment, les conseqüències serien nefastes i la idea, malgrat ser del tot absurda, la fa somriure. No deixa de ser graciós com els humans, aparentment amos i senyors del planeta, depenem d'aquestes formes de vida microscòpica per viure. La humanitat utilitza els llevats, els fongs i els bacteris des de molt abans de conèixer-ne la seva existència.
 |
Tines de la Vall del Flequer (Bages), destinades a la producció de vi a mitjans del s.XIX. Foto: Salut Vila, octubre de 2017 |
El llevat Saccharomyces cerevisiae ens ha acompanyat des de temps antics, oferint-nos el producte de la seva fermentació per elaborar pa, vi i cervesa. Civilitzacions com l'egípcia consideraven la cervesa com la beguda dels déus.
Els bacteris làctics, Lactobacillus i Streptococcus, viatjaven dins els sacs de llet fresca dels pobles nòmades de l'antiga Tràcia, actual Bulgària, cap al 4.500 aC. L'escalfor i el contacte de la llet amb la pell del sac mentre recorrien camins, creava un ambient idoni perquè els bacteris transformessin la lactosa de la llet en àcid làctic, donant lloc als primers iogurts de la història.
 |
Colònies de Penicillium sobre agar SDA. Foto: Salut Vila |
Fongs com Penicillium roqueforti permeten l'elaboració de potents formatges dels quals ja en parlava Plini el Vell l'any 76 dC. Curiosament, Penicillium és també el protagonista de la serendipitat de Fleming, de la qual van derivar els primers antibiòtics. Si bé l'ús de floridures provinents d'aliments o del terra per curar ferides ja era present en cultures tant distants com l'antiga Grècia, la Índia, la Xina, Rússia o els nadius nord-americans, va ser a partir de l'aïllament de substàncies antibiòtiques, anomenades penicil·lines pel fong Penicillium, que la medicina va fer un pas de gegant, esdevenint la penicil·lina el medicament que ha salvat més vides de la història.
Salvar vides. Els mots ressonen al seu cap. La mirada fixa en el bioreactor. A l'interior, un medi de cultiu conté els nutrients necessaris pel creixement de Clostridium botulinum. Els seus ingredients preferits i un estricte control de temperatura i pH, afavoreixen que es multipliqui i produeixi la seva característica toxina. Habitant de sòls i aigües estancades, aquest bacteri té la particularitat de formar espores altament resistents, que li permeten sobreviure a altes temperatures i en absència d'oxigen. La toxina generada per aquest bacil, amagada en conserves mal elaborades, ens pot provocar la mort, però produïda i administrada sota control permet tractar malalties neurològiques associades a hiperactivitat muscular o ser usada en tractaments d'estètica, el famós bòtox. Al laboratori on treballa però, el destí és molt diferent. S'estremeix cada cop que hi pensa. Si visqués com els microorganismes, aliens a les conseqüències de la seva activitat, o com la majoria dels seus companys de feina, que ignoren els objectius reals de l'empresa, no tindria aquest pes a la consciència. Però ella sap la veritat.
 |
Representació de malalts de verola (Mèxic, 1538). Font: Revista chilena de infectología |
I mentalment repassa els episodis de la història en què l'afany absurd i incomprensible dels humans per la guerra ha convertit els microorganismes en armes cruels i silencioses. Veu les forces colonials escampant el virus de la verola entre les poblacions indígenes americanes.
S'esgarrifa pensant que les tropes russes van llençar cadàvers infectats de pesta sobre Tallin l'any 1710. Recorda com el govern alemany va enviar cartes contaminades amb Bacillus anthracis a Finlàndia, Romania, Estats Units i l'Argentina, durant la Primera Guerra Mundial.
Per no parlar dels esgarrifosos experiments amb agents biològics en éssers humans perpetrats per la Unitat 731 de l'Exèrcit Imperial japonès entre 1937 i 1945. Tristament, la part més fosca de la humanitat segueix fent camí i les toxines generades en el bioreactor que té al davant seran usades amb finalitats bèl·liques.
 |
Bioreactor destinat a la producció de biopesticides a partir de residus orgànics urbans. Font: Universitat Autònoma de Barcelona. |
Aleshores ho veu clar. Els microorganismes no deixaran de treballar mentre les condicions siguin les òptimes, però ella sí que pot fer que tot s'aturi. Mira al seu voltant, està sola. Amb un rampell, desconnecta el bioreactor. En poques hores, els nutrients s'esgotaran i el cultiu no prosperarà. Ràpidament es treu la bata i abandona el laboratori. A fora, l'inunda una intensa olor de terra mullada. Són els bacteris del bosc fabricant geosmina lliurement, regalant-li el millor bàlsam per a la seva fugida.
Aquest text participa en el blog de narrativa científica Café Hypatia amb el tema #PVlucesysombras
___________________________________________________
¿Qué pasaría si un día todos los microorganismos que trabajan para nosotros se declarasen en huelga? ¿Si cansados de ser explotados, de vivir bajo la presión de tener que mantener el ritmo de producción, detuviesen su multiplicación y su metabolismo? Lo piensa mientras comprueba el funcionamiento del bioreactor, en el cual millones de bacterias crecen y se multiplican exponencialmente. Se imagina a maestros queseros, yogurteros y enólogos desconcertados al ver quesos que no maduran, leche que no forma yogur, tinas donde el mosto no fermenta. Se imagina a técnicos de laboratorio desesperados porque no obtienen los cultivos deseados, deteniéndose la producción de antibióticos, de vacunas, de probióticos, de biofertilizantes y biopesticidas. Realmente, las consecuencias serían nefastas y la idea, a pesar de ser totalmente absurda, la hace sonreir. No deja de ser gracioso como los humanos, aparentemente amos y señores del planeta, dependemos de estas formas de vida microscópica para vivir. La humanidad utiliza las levaduras, los hongos y las bacterias desde mucho antes de conocer su existencia.
 |
Tinas de la Vall del Flequer (Bages), destinadas a la producción de vino a mediados del s.XIX. Foto: Salut Vila, octubre de 2017
|
La levadura Saccharomyces cerevisiae nos ha acompañado desde tiempos antiguos, ofreciéndonos el producto de su fermentación para elaborar pan, vino y cerveza. Civilizaciones como la egípcia consideraban la cerveza como la bebida de los dioses.
Las bacterias lácticas, Lactobacillus y Streptococcus, viajaban dentro de los sacos de leche fresca de los pueblos nómadas de la antigua Tracia, actual Bulgaria, en torno al 4.500 aC. El calor y el contacto de la leche con la piel del saco mientras recorrían caminos, creaba un ambiente idóneo para que las bacterias transformasen la lactosa de la leche en ácido láctico, dando lugar a los primeros yogures de la historia.
|
Colonias de Penicillium sobre agar SDA. Foto: Salut Vila
|
Hongos como
Penicillium roqueforti permiten la elaboración de potentes quesos de los cuales ya hablaba Plinio el Viejo en el año 76 dC. Curiosamente,
Penicillium es también el protagonista de la serendipia de Fleming, de la cual derivaron los primeros antibióticos. Aunque el uso de mohos provinientes de alimentos o del suelo para curar heridas ya era presente en culturas tan distantes como la antigua Grecia, la Índia, la China, Rusia o los nativos norteamericanos, fue a partir del aislamiento de sustancias antibióticas, denominadas penicilinas por el hongo
Penicillium, que la medicina hizo un paso de gigante, conviertiendo la penicilina en el medicamento que ha salvado más vidas de la historia.
Salvar vidas. Las palabras retumban en su cabeza. La mirada fija en el bioreactor. En su interior, un medio de cultivo contiene los nutrientes necesarios para el crecimiento de Clostridium botulinum. Sus ingredientes favoritos y un estricto control de temperatura y pH, favorecen su multiplicación y la producción de su característica toxina. Habitante de suelos y aguas estancadas, esta bacteria tiene la particularidad de formar esporas altamente resistentes, que le permiten sobrevivir a altas temperaturas y en ausencia de oxígeno. La toxina generada por este bacilo, escondida en conservas mal elaboradas, nos puede provocar la muerte, pero producida y administrada bajo control permite tratar enfermedades neurológicas asociadas a hiperactividad muscular o ser usada en tratamientos de estética, el famoso bótox. Sin embargo, en el laboratorio donde trabaja el destino es muy distinto. Se estremece cada vez que lo piensa. Si viviera como los microorganismos, ajenos a las consecuencias de su actividad, o como la mayoría de sus compañeros de trabajo, que ignoran los objectivos reales de la empresa, no tendría este peso en la consciencia. Pero ella conoce bien la verdad.
 |
Representación de enfermos de viruela (México, 1538). Fuente: Revista chilena de infectología |
Y mentalmente repasa los episodios de la historia en los que el afán absurdo e incomprensible de los humanos por la guerra ha convertido a los microorganismos en armas crueles y silenciosas. Ve las fuerzas coloniales esparciendo el virus de la viruela entre las poblaciones indígenas americanas. Se estremece pensando como las tropas rusas arrojaron cadáveres infectados de peste sobre Tallin en 1710. Recuerda como el gobierno alemán envió cartas contaminadas con Bacillus anthracis a Finlandia, Rumanía, Estados Unidos y Argentina, durante la Primera Guerra Mundial. Por no hablar de los atroces experimentos con agentes biológicos en seres humanos perpetrados por la Unidad 731 del Ejército Imperial Japonés entre 1937 y 1945. Tristemente, la parte más oscura de la humanidad sigue haciendo camino y las toxinas generadas en el bioreactor que tiene enfrente seran usadas con fines bélicos.
 |
Bioreactor destinado a la producción de biopesticidas a partir de residuos orgánicos urbanos. Fuente: Universitat Autònoma de Barcelona. |
Entonces lo ve claro. Los microorganismos no dejaran de trabajar mientras las condiciones sean las óptimas, pero ella sí que puede hacer que todo se detenga. Mira a su alrededor, está sola. En un arrebato, desconecta el bioreactor. En pocas horas, los nutrientes se agotaran y el cultivo no prosperará. Rápidamente se quita la bata y abandona el laboratorio. Fuera, la inunda un intenso olor a tierra mojada. Son las bacterias del bosque fabricando geosmina libremente, regalándole el mejor bálsamo para su fuga.
Este texto participa en el blog de narrativa científica Café Hypatia con el tema #PVlucesysombras